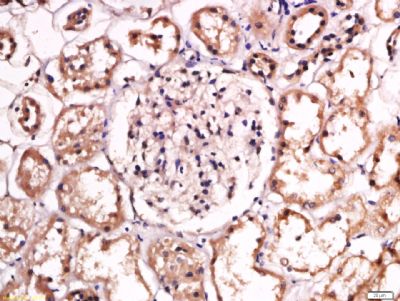
产品细节图片1

相关产品推荐更多 >
万千商家帮你免费找货
0 人在求购买到急需产品
- 详细信息
- 文献和实验
- 技术资料
- 供应商:
上海联迈生物工程有限公司
- 库存:
大量
- 目录编号:
LM-10784R
- 克隆性:
多克隆
- 抗原来源:
Rabbit
- 保质期:
1年
- 抗体英文名:
SPTBN2
- 抗体名:
非红细胞血影脑蛋白β2/spectrin β III抗体
- 宿主:
Rabbit
- 适应物种:
Human, Mouse, Rat, Dog, Cow, Rabbit, Sheep,
- 免疫原:
KLH conjugated synthetic peptide derived from human SPTBN2:71-170/2390
- 亚型:
IgG
- 形态:
Lyophilized or Liquid
- 应用范围:
WB=1:500-2000 ELISA=1:500-1000 IHC-P=1:400-800 IHC-F=1:400-800 ICC=1:100-500 IF=1:100-500 (石蜡切片需做抗原修复)
- 浓度:
1mg/ml
- 保存条件:
Store at -20 °C
- 规格:
100ul 200ul
| 英文名称 | SPTBN2 |
| 中文名称 | 非红细胞血影脑蛋白β2/spectrin β III抗体 |
| 别 名 | Beta III spectrin; Beta-III spectrin; SCA 5; SCA5; Spectrin beta chain brain 2; Spectrin beta non erythrocytic 2; Spectrin non erythroid beta chain 2; Spinocerebellar ataxia 5; SPTBN 2; Spectrin beta chain, non-erythrocytic 2; Beta-III spectrin; Spinocerebellar ataxia 5 protein; SPTN2_HUMAN. |
| 规格价格 | 100ul/1380元 购买 200ul/2200元 购买 大包装/询价 |
| 说 明 书 | 100ul 200ul |
| 研究领域 | 神经生物学 信号转导 细胞骨架 |
| 抗体来源 | Rabbit |
| 克隆类型 | Polyclonal |
| 交叉反应 | Human, Mouse, Rat, Dog, Cow, Rabbit, Sheep, |
| 产品应用 | WB=1:500-2000 ELISA=1:500-1000 IHC-P=1:400-800 IHC-F=1:400-800 ICC=1:100-500 IF=1:100-500 (石蜡切片需做抗原修复) not yet tested in other applications. optimal dilutions/concentrations should be determined by the end user. |
| 分 子 量 | 271kDa |
| 细胞定位 | 细胞浆 |
| 性 状 | Lyophilized or Liquid |
| 浓 度 | 1mg/ml |
| 免 疫 原 | KLH conjugated synthetic peptide derived from human SPTBN2:71-170/2390 |
| 亚 型 | IgG |
| 纯化方法 | affinity purified by Protein A |
| 储 存 液 | 0.01M TBS(pH7.4) with 1% BSA, 0.03% Proclin300 and 50% Glycerol. |
| 保存条件 | Store at -20 °C for one year. Avoid repeated freeze/thaw cycles. The lyophilized antibody is stable at room temperature for at least one month and for greater than a year when kept at -20°C. When reconstituted in sterile pH 7.4 0.01M PBS or diluent of antibody the antibody is stable for at least two weeks at 2-4 °C. |
| PubMed | PubMed |
| 产品介绍 | background: Spectrin is an actin binding protein that is a major component of the plasma membrane skeleton. Spectrins function as membrane organizers and stabilizers by forming dimers, tetramers and higher polymers. Spectrin Alpha and spectrin Beta are present in erythrocytes, whereas spectrin Alpha II (also designated fodrin Alpha) and spectrin Beta I (also designated fodrin Beta) are present in other somatic cells. The spectrin tetramers in erythrocytes act as barriers to lateral diffusion, but spectrin dimers seem to lack this function. Spectrin Beta III is highly homologous to both spectrin Beta I and spectrin Beta II. Western blot analysis shows that spectrin Beta III migrates at a higher molecular mass than predicted in the kidney. Spectrin Beta III is highly expressed in brain, kidney, pancreas, and liver, and at lower levels in lung and placenta. Specifically, spectrin Beta III constitutes a major component of the Golgi and vesicular membrane skeletons. Function: Probably plays an important role in neuronal membrane skeleton. Subcellular Location: Cytoplasm, cytoskeleton. Cytoplasm, cell cortex. Tissue Specificity: Highly expressed in brain, kidney, pancreas, and liver, and at lower levels in lung and placenta. DISEASE: Defects in SPTBN2 are the cause of spinocerebellar ataxia type 5 (SCA5) [MIM:600224]. Spinocerebellar ataxia is a clinically and genetically heterogeneous group of cerebellar disorders. Patients show progressive incoordination of gait and often poor coordination of hands, speech and eye movements, due to degeneration of the cerebellum with variable involvement of the brainstem and spinal cord. SCA5 is an autosomal dominant cerebellar ataxia (ADCA). It is a slowly progressive disorder with variable age at onset, ranging between 10 and 50 years. Similarity: Belongs to the spectrin family. Contains 2 CH (calponin-homology) domains. Contains 1 PH domain. Contains 17 spectrin repeats. SWISS: O15020 Gene ID: 6712 Database links: Entrez Gene: 6712 Human Omim: 604985 Human SwissProt: O15020 Human Unigene: 26915 Human Important Note: This product as supplied is intended for research use only, not for use in human, therapeutic or diagnostic applications. |
| 产品图片 | Tissue/cell: human kidney tissue; 4% Paraformaldehyde-fixed and paraffin-embedded; Antigen retrieval: citrate buffer ( 0.01M, pH 6.0 ), Boiling bathing for 15min; Block endogenous peroxidase by 3% Hydrogen peroxide for 30min; Blocking buffer (normal goat serum,C-0005) at 37℃ for 20 min; Incubation: Anti-SPTBN2 Polyclonal Antibody, Unconjugated(bs-10784R) 1:200, overnight at 4°C, followed by conjugation to the secondary antibody(SP-0023) and DAB(C-0010) staining  Tissue/cell: rat brain tissue; 4% Paraformaldehyde-fixed and paraffin-embedded; Antigen retrieval: citrate buffer ( 0.01M, pH 6.0 ), Boiling bathing for 15min; Block endogenous peroxidase by 3% Hydrogen peroxide for 30min; Blocking buffer (normal goat serum,C-0005) at 37℃ for 20 min; Incubation: Anti-SPTBN2 Polyclonal Antibody, Unconjugated(bs-10784R) 1:200, overnight at 4°C, followed by conjugation to the secondary antibody(SP-0023) and DAB(C-0010) staining |
风险提示:丁香通仅作为第三方平台,为商家信息发布提供平台空间。用户咨询产品时请注意保护个人信息及财产安全,合理判断,谨慎选购商品,商家和用户对交易行为负责。对于医疗器械类产品,请先查证核实企业经营资质和医疗器械产品注册证情况。
 文献和实验
文献和实验大豆β-伴球蛋白(β-conglycinin)酶联免疫分析(ELISA)
大豆β- 伴球蛋白( β-conglycinin) 酶联免疫分析( ELISA ) 试剂盒使用说明书 本试剂仅供研究使用 目的:本试剂盒用于测定植物组织,细胞及其它相关样本中β- 伴球蛋白( β-conglycinin) 含量。 实验原理: 本试剂盒应用双抗体夹心法测定标本中大豆β - 伴球蛋白 ( β -conglycinin) 水平。用纯化的大豆β - 伴球蛋白 ( β
人 β-内啡肽 ( β- EP) 酶联免疫 分析( ELISA ) 试剂 盒使用说明书 本试剂仅供研究使用 目的:本试剂盒用于测定人血清,血浆及相关液体样本中 β-内啡肽(β-EP) 的 含量。 实验原理 : 本试剂盒应用双抗体夹心法测定 标本 中 人 β-内啡肽 ( β- EP) 水平。用纯化的 人 β-内啡肽 ( β- EP) 抗体包被微孔板,制成固相抗体,往包被单抗的微孔中依次加入 β-内啡肽
小鼠β-肌动蛋白(β-actin)酶联免疫分析(ELISA)
小鼠β- 肌动蛋白 ( β -actin) 酶联免疫 分析( ELISA ) 试剂 盒使用说明书 本试剂仅供研究使用 目的:本试剂盒用于测定小鼠血清,血浆及相关液体样本中 β-肌动蛋白(β-actin) 含量。 实验原理 : 本试剂盒应用双抗体夹心法测定 标本 中 小鼠β- 肌动蛋白 ( β -actin) 水平。用纯化的 小鼠β- 肌动蛋白 ( β -actin) 抗体包被微孔板,制成固相抗体,往包被单抗的微孔
 技术资料
技术资料暂无技术资料 索取技术资料










